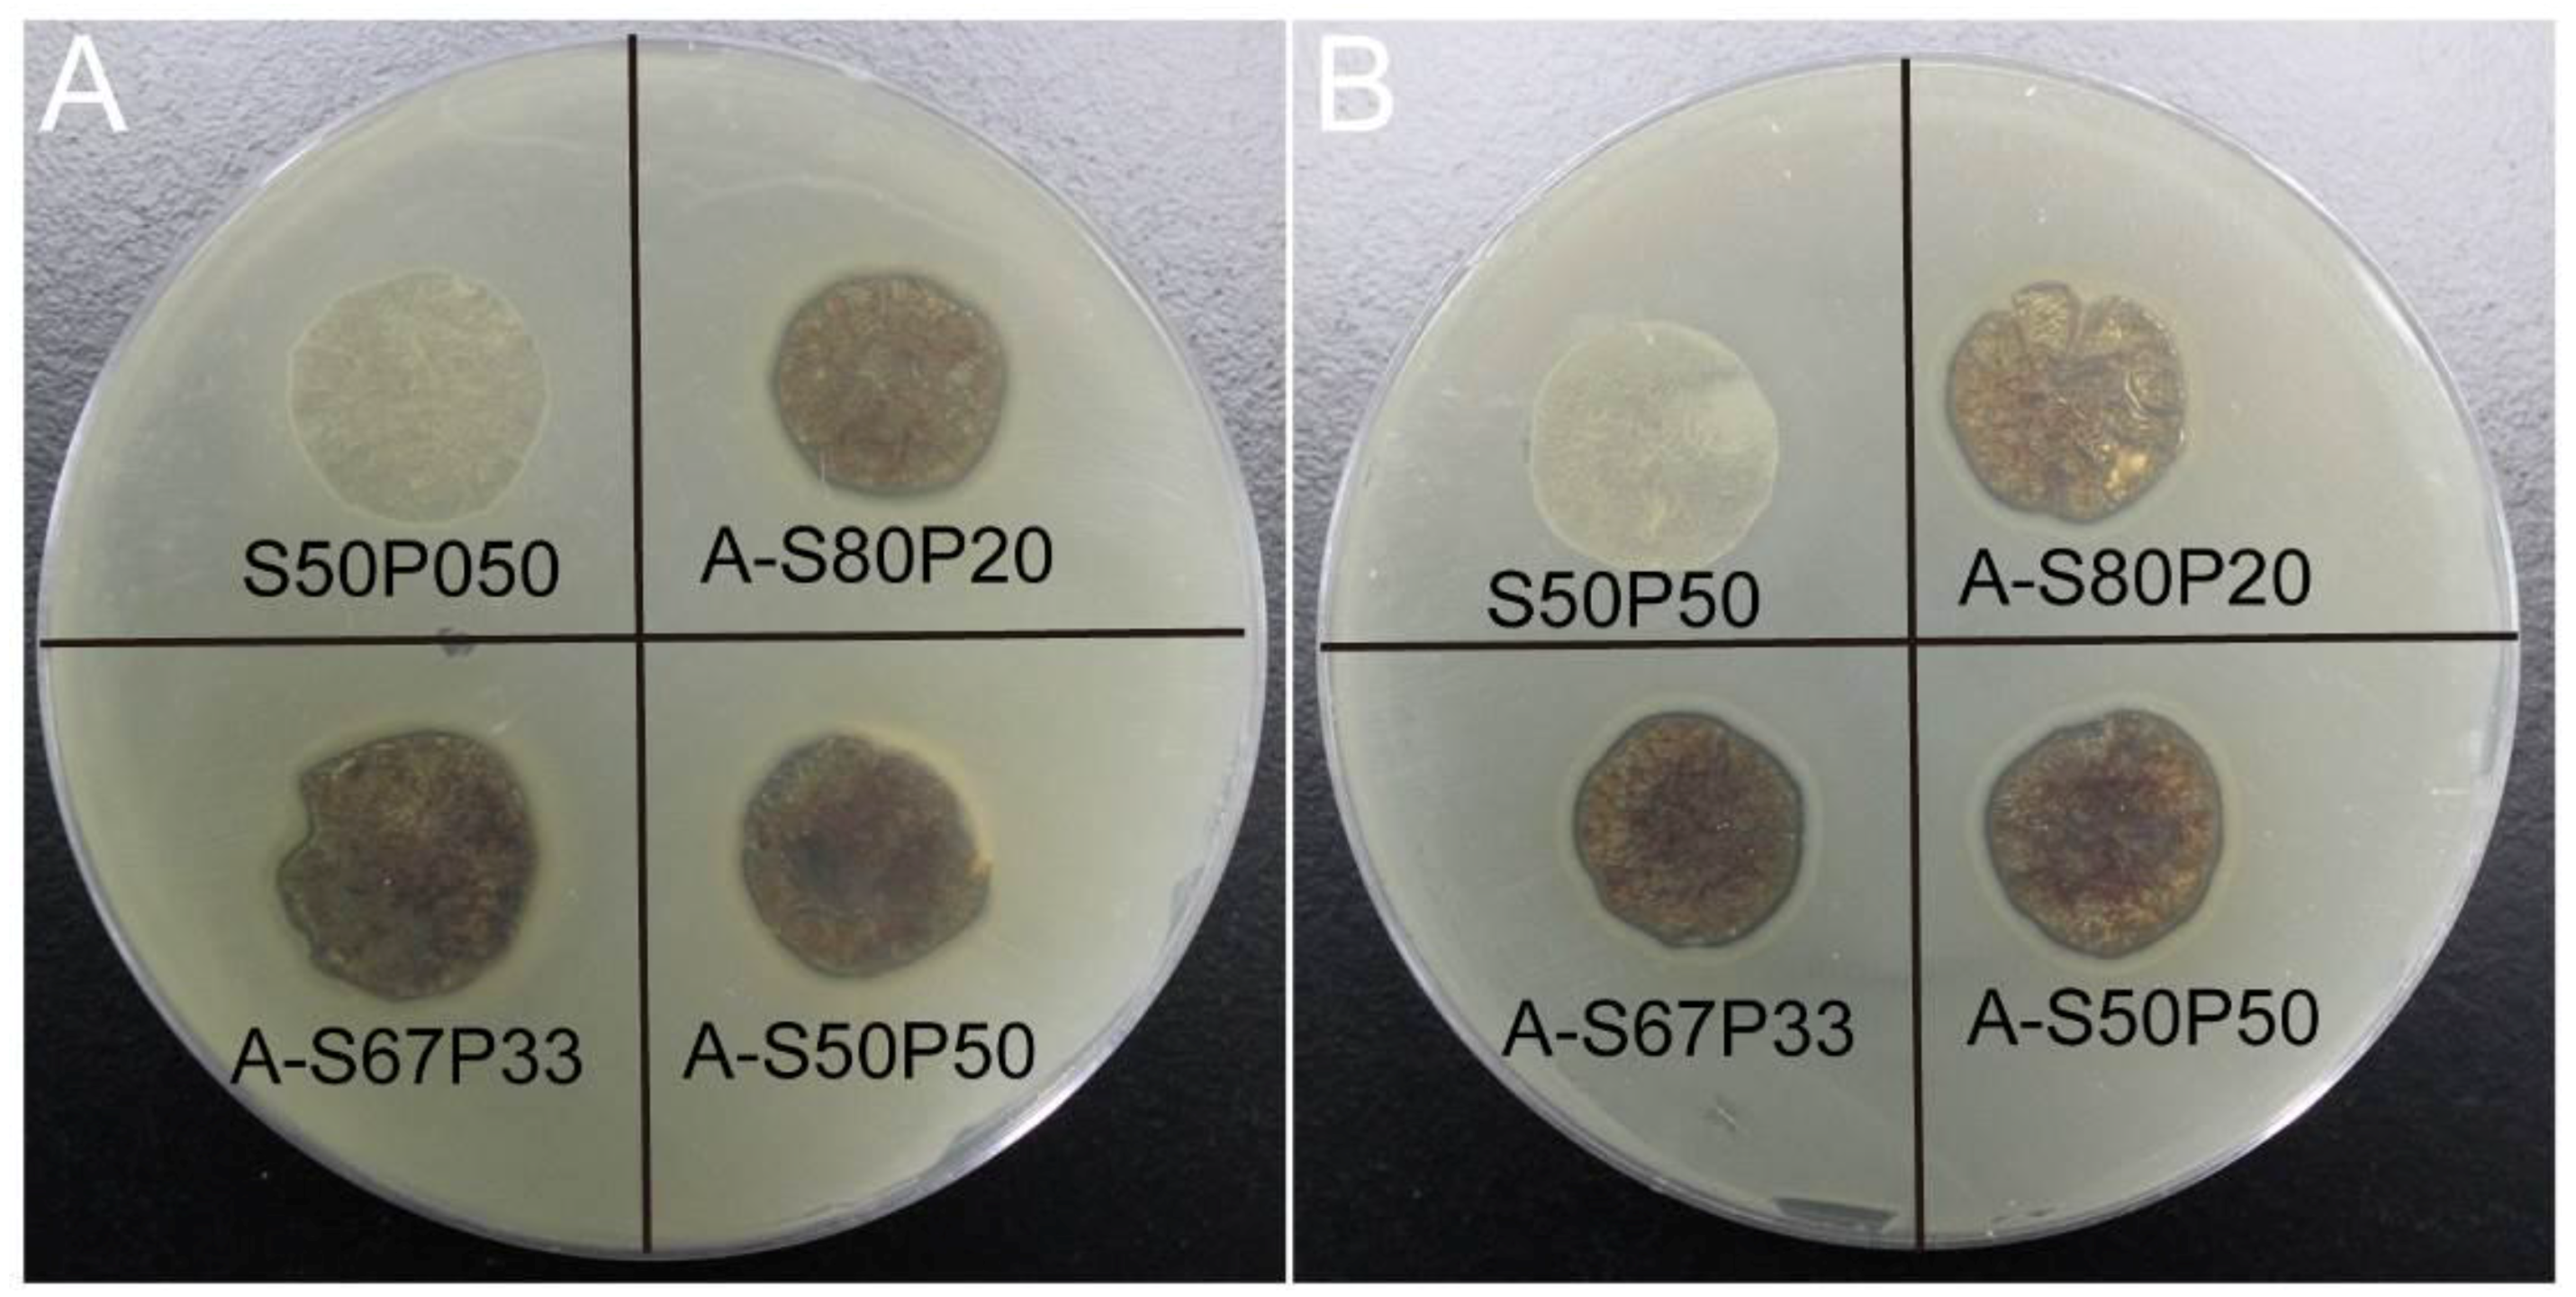
Materials 10 00667 g009

Biosynthesis and Characterization of AgNPs–Silk/PVA Film for Potential Packaging Application
Abstract
:1. Introduction
2. Results and Discussion
2.1. Preparation of AgNPs–Silk/PVA Film
2.2. Characterization of Silk Fibroin
2.3. Stability of AgNPs–Silk Fibroin Solution
2.4. Characterization of AgNPs–Silk/PVA Film
2.5. Mechanical Property of AgNPs–Silk/PVA Film
2.6. Hydrophobicity Measurement
2.7. Antibacterial Assay of AgNPs–Silk/PVA Film
2.8. Degradation of AgNPs–Silk/PVA Film
3. Materials and Methods
3.1. Materials
3.2. Preparation of Regenerated Silk Fibroin Solution
3.3. Synthesis of AgNPs
3.4. Preparation of AgNPs–Silk/PVA Film
3.5. Characterization of AgNPs–Silk/PVA Film
3.6. Bacterial Growth Curve Assay
3.7. Inhibition Zone Assay
3.8. In Vitro Degradation Analysis
4. Conclusions
Acknowledgments
Author Contributions
Conflicts of Interest
References
- De Azeredo, H.M.C. Nanocomposites for food packaging applications. Food Res. Int. 2009, 42, 1240–1253. [Google Scholar] [CrossRef]
- Rhim, J.W.; Park, H.M.; Ha, C.S. Bio-nanocomposites for food packaging applications. Prog. Polym. Sci. 2013, 38, 1629–1652. [Google Scholar] [CrossRef]
- Kasirga, Y.; Oral, A.; Caner, C. Preparation and characterization of chitosan/montmorillonite- k10 nanocomposites films for food packaging applications. Polym. Compos. 2012, 33, 1874–1882. [Google Scholar] [CrossRef]
- Heydari, A.; Alemzadeh, I.; Vossoughi, M. Functional properties of biodegradable corn starch nanocomposites for food packaging applications. Mater. Des. 2013, 50, 954–961. [Google Scholar] [CrossRef]
- Butnaru, E.; Cheaburu, C.N.; Yilmaz, O.; Pricope, G.M.; Vasile, C. Poly(vinyl alcohol)/chitosan/montmorillonite nanocomposites for food packaging applications: Influence of montmorillonite content. High Perform. Polym. 2016, 28, 1124–1138. [Google Scholar] [CrossRef]
- Munoz-Bonilla, A.; Fernandez-Garcia, M. Polymeric materials with antimicrobial activity. Prog. Polym. Sci. 2012, 37, 281–339. [Google Scholar] [CrossRef]
- Duncan, T.V. Applications of nanotechnology in food packaging and food safety: Barrier materials, antimicrobials and sensors. J. Colloid Interface Sci. 2011, 363, 1–24. [Google Scholar] [CrossRef] [PubMed]
- Sanuja, S.; Agalya, A.; Umapathy, M.J. Synthesis and characterization of zinc oxide-neem oil-chitosan bionanocomposite for food packaging application. Int. J. Biol. Macromol. 2015, 74, 76–84. [Google Scholar] [CrossRef] [PubMed]
- Ollier, R.P.; Perez, C.J.; Alvarez, V.A. Preparation and characterization of micro and nanocomposites based on poly(vinyl alcohol) for packaging applications. J. Mater. Sci. 2013, 48, 7088–7096. [Google Scholar] [CrossRef]
- Mihindukulasuriya, S.D.F.; Lim, L.T. Oxygen detection using uv-activated electrospun poly(ethylene oxide) fibers encapsulated with tio2 nanoparticles. J. Mater. Sci. 2013, 48, 5489–5498. [Google Scholar] [CrossRef]
- Palza, H. Antimicrobial polymers with metal nanoparticles. Int. J. Mol. Sci. 2015, 16, 2099–2116. [Google Scholar] [CrossRef] [PubMed]
- Munoz-Bonilla, A.; Fernandez-Garcia, M. The roadmap of antimicrobial polymeric materials in macromolecular nanotechnology. Eur. Polym. J. 2015, 65, 46–62. [Google Scholar] [CrossRef]
- Lu, Z.; Gao, J.T.; He, Q.F.; Wu, J.; Liang, D.H.; Yang, H.; Chen, R. Enhanced antibacterial and wound healing activities of microporous chitosan-Ag/ZnO composite dressing. Carbohydr. Polym. 2017, 156, 460–469. [Google Scholar] [CrossRef] [PubMed]
- Alvarez-Paino, M.; Munoz-Bonilla, A.; Fernandez-Garcia, M. Antimicrobial polymers in the nano-world. Nanomaterials 2017, 7, 48. [Google Scholar] [CrossRef] [PubMed]
- Yin, J.; Yang, Y.; Hu, Z.Q.; Deng, B.L. Attachment of silver nanoparticles (AgNPs) onto thin-film composite (TFC) membranes through covalent bonding to reduce membrane biofouling. J. Membr. Sci. 2013, 441, 73–82. [Google Scholar] [CrossRef]
- Mann, S. Molecular tectonics in biomineralization and biomimetic materials chemistry. Nature 1993, 365, 499–505. [Google Scholar] [CrossRef]
- Weiner, S.; Addadi, L. Design strategies in mineralized biological materials. J. Mater. Chem. 1997, 7, 689–702. [Google Scholar] [CrossRef]
- Addadi, L.; Weiner, S. Biomineralization—A pavement of pearl. Nature 1997, 389, 912–915. [Google Scholar] [CrossRef]
- Zhao, S.; Yao, J.R.; Fei, X.; Shao, Z.Z.; Chen, X. An antimicrobial film by embedding in situ synthesized silver nanoparticles in soy protein isolate. Mater. Lett. 2013, 95, 142–144. [Google Scholar] [CrossRef]
- Zhou, Y.; Kogiso, M.; Asakawa, M.; Dong, S.; Kiyama, R.; Shimizu, T. Antimicrobial nanotubes consisting of ag-embedded peptidic lipid-bilayer membranes as delivery vehicles. Adv. Mater. 2009, 21, 1742–1745. [Google Scholar] [CrossRef]
- Fei, X.; Li, W.; Shao, Z.Z.; Seeger, S.; Zhao, D.Y.; Chen, X. Protein biomineralized nanoporous inorganic mesocrystals with tunable hierarchical nanostructures. J. Am. Chem. Soc. 2014, 136, 15781–15786. [Google Scholar] [CrossRef] [PubMed]
- Wang, Y.Z.; Kim, U.J.; Blasioli, D.J.; Kim, H.J.; Kaplan, D.L. In vitro cartilage tissue engineering with 3D porous aqueous-derived silk scaffolds and mesenchymal stem cells. Biomaterials 2005, 26, 7082–7094. [Google Scholar] [CrossRef] [PubMed]
- Wang, Y.Z.; Kim, H.J.; Vunjak-Novakovic, G.; Kaplan, D.L. Stem cell-based tissue engineering with silk biomaterials. Biomaterials 2006, 27, 6064–6082. [Google Scholar] [CrossRef] [PubMed]
- Vepari, C.; Kaplan, D.L. Silk as a biomaterial. Prog. Polym. Sci. 2007, 32, 991–1007. [Google Scholar] [CrossRef] [PubMed]
- Fei, X.; Shao, Z.Z.; Chen, X. Synthesis of hierarchical three-dimensional copper oxide nanostructures through a biomineralization-inspired approach. Nanoscale 2013, 5, 7991–7997. [Google Scholar] [CrossRef] [PubMed]
- Mi, R.X.; Liu, Y.X.; Chen, X.; Shao, Z.Z. Structure and properties of various hybrids fabricated by silk nanofibrils and nanohydroxyapatite. Nanoscale 2016, 8, 20096–20102. [Google Scholar] [CrossRef] [PubMed]
- Selvakannan, P.R.; Swami, A.; Srisathiyanarayanan, D.; Shirude, P.S.; Pasricha, R.; Mandale, A.B.; Sastry, M. Synthesis of aqueous au core-ag shell nanoparticles using tyrosine as a pH-dependent reducing agent and assembling phase-transferred silver nanoparticles at the air-water interface. Langmuir 2004, 20, 7825–7836. [Google Scholar] [CrossRef] [PubMed]
- Liu, B.; Xu, H.; Zhao, H.Y.; Liu, W.; Zhao, L.Y.; Li, Y. Preparation and characterization of intelligent starch/PVA films for simultaneous colorimetric indication and antimicrobial activity for food packaging applications. Carbohydr. Polym. 2017, 157, 842–849. [Google Scholar] [CrossRef] [PubMed]
- Chiellini, E.; Cinelli, P.; Chiellini, F.; Imam, S.H. Environmentally degradable bio-based polymeric blends and composites. Macromol. Biosci. 2004, 4, 218–231. [Google Scholar] [CrossRef] [PubMed]
- Dailey, L.A.; Wittmar, M.; Kissel, T. The role of branched polyesters and their modifications in the development of modern drug delivery vehicles. J. Control. Release 2005, 101, 137–149. [Google Scholar] [CrossRef] [PubMed]
- Cano, A.; Fortunati, E.; Chafer, M.; Gonzalez-Martinez, C.; Chiralt, A.; Kenny, J.M. Effect of cellulose nanocrystals on the properties of pea starch-poly(vinyl alcohol) blend films. J. Mater. Sci. 2015, 50, 6979–6992. [Google Scholar] [CrossRef]
- Zhou, Y.; Chen, W.X.; Itoh, H.; Naka, K.; Ni, Q.Q.; Yamane, H.; Chujo, Y. Preparation of a novel core-shell nanostructured gold colloid-silk fibroin bioconjugate by the protein in situ redox technique at room temperature. Chem. Commun. 2001, 23, 2518–2519. [Google Scholar] [CrossRef]
- Xie, J.P.; Lee, J.Y.; Wang, D.I.C.; Ting, Y.P. Silver nanoplates: From biological to biomimetic synthesis. ACS Nano 2007, 1, 429–439. [Google Scholar] [CrossRef] [PubMed]
- Fei, X.; Jia, M.H.; Du, X.; Yang, Y.H.; Zhang, R.; Shao, Z.Z.; Zhao, X.; Chen, X. Green synthesis of silk fibroin-silver nanoparticle composites with effective antibacterial and biofilm-disrupting properties. Biomacromolecules 2013, 14, 4483–4488. [Google Scholar] [CrossRef] [PubMed]
- Gil, E.S.; Hudson, S.M. Effect of silk fibroin interpenetrating networks on swelling/deswelling kinetics and rheological properties of poly(n-isopropylacrylamide) hydrogels. Biomacromolecules 2007, 8, 258–264. [Google Scholar] [CrossRef] [PubMed]
- Yao, M.Z.; Huang-Fu, M.Y.; Liu, H.N.; Wang, X.R.; Sheng, X.X.; Gao, J.Q. Fabrication and characterization of drug-loaded nano-hydroxyapatite/polyamide 66 scaffolds modified with carbon nanotubes and silk fibroin. Int. J. Nanomed. 2016, 11, 6181–6194. [Google Scholar] [CrossRef] [PubMed]
- Wang, X.Q.; Yucel, T.; Lu, Q.; Hu, X.; Kaplan, D.L. Silk nanospheres and microspheres from silk/PVA blend films for drug delivery. Biomaterials 2010, 31, 1025–1035. [Google Scholar] [CrossRef] [PubMed]
- Pour, Z.S.; Makvandi, P.; Ghaemy, M. Performance properties and antibacterial activity of crosslinked films of quaternary ammonium modified starch and poly(vinyl alcohol). Int. J. Biol. Macromol. 2015, 80, 596–604. [Google Scholar] [CrossRef] [PubMed]
- Madera-Santana, T.J.; Freile-Pelegrin, Y.; Azamar-Barrios, J.A. Physicochemical and morphological properties of plasticized poly(vinyl alcohol)-agar biodegradable films. Int. J. Biol. Macromol. 2014, 69, 176–184. [Google Scholar] [CrossRef] [PubMed]
- Li, X.G.; Wu, L.Y.; Huang, M.R.; Shao, H.L.; Hu, X.C. Conformational transition and liquid crystalline state of regenerated silk fibroin in water. Biopolymers 2008, 89, 497–505. [Google Scholar] [CrossRef] [PubMed]
- Partlow, B.P.; Bagheri, M.; Harden, J.L.; Kaplan, D.L. Tyrosine templating in the self-assembly and crystallization of silk fibroin. Biomacromolecules 2016, 17, 3570–3579. [Google Scholar] [CrossRef] [PubMed]
- Lok, C.N.; Ho, C.M.; Chen, R.; He, Q.Y.; Yu, W.Y.; Sun, H.; Tam, P.K.H.; Chiu, J.F.; Che, C.M. Silver nanoparticles: Partial oxidation and antibacterial activities. J. Biol. Inorg. Chem. 2007, 12, 527–534. [Google Scholar] [CrossRef] [PubMed]
- Burda, C.; Chen, X.B.; Narayanan, R.; El-Sayed, M.A. Chemistry and properties of nanocrystals of different shapes. Chem. Rev. 2005, 105, 1025–1102. [Google Scholar] [CrossRef] [PubMed]
- Drury, A.; Chaure, S.; Kroell, M.; Nicolosi, V.; Chaure, N.; Blau, W.J. Fabrication and characterization of silver/polyaniline composite nanowires in porous anodic alumina. Chem. Mater. 2007, 19, 4252–4258. [Google Scholar] [CrossRef]
- Feng, X.X.; Zhang, L.L.; Chen, J.Y.; Guo, Y.H.; Zhang, H.P.; Jia, C.I. Preparation and characterization of novel nanocomposite films formed from silk fibroin and nano-TiO2. Int. J. Biol. Macromol. 2007, 40, 105–111. [Google Scholar] [CrossRef] [PubMed]
- Meng, M.; He, H.W.; Xiao, J.; Zhao, P.; Xie, J.L.; Lu, Z.S. Controllable in situ synthesis of silver nanoparticles on multilayered film-coated silk fibers for antibacterial application. J. Colloid Interface Sci. 2016, 461, 369–375. [Google Scholar] [CrossRef] [PubMed]
- Tao, G.; Wang, Y.J.; Liu, L.N.; Chang, H.P.; Zhao, P.; He, H.W. Preparation and characterization of silver nanoparticles composited on polyelectrolyte film coated sericin gel for enhanced antibacterial application. Sci. Adv. Mater. 2016, 8, 1547–1552. [Google Scholar] [CrossRef]
- Cai, R.; Tao, G.; He, H.; Song, K.; Zuo, H.; Jiang, W.; Wang, Y. One-step synthesis of silver nanoparticles on polydopamine-coated sericin/polyvinyl alcohol composite films for potential antimicrobial applications. Molecules 2017, 22, 721. [Google Scholar] [CrossRef] [PubMed]

© 2017 by the authors. Licensee MDPI, Basel, Switzerland. This article is an open access article distributed under the terms and conditions of the Creative Commons Attribution (CC BY) license (http://creativecommons.org/licenses/by/4.0/).
Share and Cite
Tao, G.; Cai, R.; Wang, Y.; Song, K.; Guo, P.; Zhao, P.; Zuo, H.; He, H. Biosynthesis and Characterization of AgNPs–Silk/PVA Film for Potential Packaging Application. Materials 2017, 10, 667. https://doi.org/10.3390/ma10060667
Tao G, Cai R, Wang Y, Song K, Guo P, Zhao P, Zuo H, He H. Biosynthesis and Characterization of AgNPs–Silk/PVA Film for Potential Packaging Application. Materials. 2017; 10(6):667. https://doi.org/10.3390/ma10060667
Chicago/Turabian StyleTao, Gang, Rui Cai, Yejing Wang, Kai Song, Pengchao Guo, Ping Zhao, Hua Zuo, and Huawei He. 2017. "Biosynthesis and Characterization of AgNPs–Silk/PVA Film for Potential Packaging Application" Materials 10, no. 6: 667. https://doi.org/10.3390/ma10060667
APA StyleTao, G., Cai, R., Wang, Y., Song, K., Guo, P., Zhao, P., Zuo, H., & He, H. (2017). Biosynthesis and Characterization of AgNPs–Silk/PVA Film for Potential Packaging Application. Materials, 10(6), 667. https://doi.org/10.3390/ma10060667




